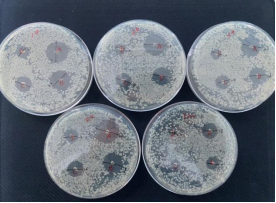
新闻图片1

微信扫一扫
关注公众号
KroVin 300 防腐剂
¥270 - 1750
产品分类
- 酶及底物 (520)
- 免疫学 (3087)
- 标准品/对照品 (536)
- 生物制药与疫苗 (604)
- 分离纯化 (37)
- 生化试剂 (28748)
- 分子生物学 (21)
- WAKO (13608)
- Jackson ImmunoResearch (2012)
- Ludger 糖链分析 (87)
- Lumiprobe活性染料 (3)
- abcam (39100)
- Merck-Sigma (44401)
- MP Bio (11006)
- 试剂 (9706)
- 健康原料 (24)
- 新型材料 (345)
- 仪器分析 (1025)
- 合作品牌 (44464)
- Aalto
- AAT Bioquest
- AbD
- Active Motif
- Advanced Targeting Systems
- Ambion
- AnaSpec
- AssayDesign
- Avanti
- Bangs Laboratories
- BioPorto
- BioSource
- bioworld
- cayman
- Chemicon
- Clontech
- CST
- DiFco
- Epigentek
- hampton
- Himedia
- Hyclone
- ldmsapp
- Innova Biosciences
- Invent
- J.T.BAKER
- KPL
- lifespan
- MRC
- Phytotech
- Pierce
- Prozyme
- Qiagen
- R&D
- Roche
- Santa Cruz
- Vector
- Worthington
- 其他分类 (9)
服务保证
西宝风采
公司新闻
西宝生物KroVin300防腐剂抑菌实验和效果 - 细菌篇
发布时间:2022-11-02 09:34 | 点击次数:794
一、实验原理
利用抑菌剂不断溶解经琼脂扩散形成不同浓度梯度,已显示其抑菌作用。实验通过抑菌圈大小判断其是否具有抑菌能力。
二、实验器材
100mm培养皿、离心管、移液器、超净台、计数板、生理盐水、生化培养箱、无菌蒸馏水、接种环、大豆酪蛋白琼脂培养基等。
菌种:
自然菌液: 吸取西宝生物实验室水槽,卫生间下水池,一楼下水管,以及大门口的养鱼池的水,一共大约20ml, 进行自然沉降,取上清液部分。
防腐剂:
1.Seebio KroVin300防腐剂(共四个批次,用P1、P2、P3、P4标识)
2.某进口品牌的P**300
2.某进口品牌的P**300
三、实验步骤
1、实验工具准备及灭菌
2、培养基制备
称取10.5g培养基干粉,加入300ml纯化水,搅拌加热煮沸至完全溶解。再加入6g的葡萄糖,搅拌溶解。向各培养皿内注入约20ml的熔化状琼脂培养基(约45℃),待其冷却,备用。
3、防腐剂配制
用蒸馏水对不同类防腐剂分别按照1:250、1:500、1:1000、1:2000配制 ,做好标记。
4、菌悬液制备
取适量菌种加入生理盐水1ml,稀释10倍,采用平板计数法,稀释,得到10^6CFU/ml浓度菌悬液。
5、试验菌接种
10^6CFU/ml试验菌悬液0.2ml,将其接种到已经倒好培养基的培养皿内,用涂布棒涂布均匀(每次使用涂布棒前酒精灯下灭菌),盖好培养皿。
6、添加防腐剂
6.1 纸片法
用镊子将圆片约5.5mm滤纸平均放置在培养皿上,每个培养皿放置4个圆滤纸(4个防腐剂浓度用)。吸取不同种类,不同浓度的防腐剂3ul,加入到圆滤纸中,让防腐剂溶液分布满整个滤纸,但又不溢出,盖好培养皿。
6.2 打孔法
在培养皿里培养基上打4个孔,用100ul枪头打孔。各孔中心之间相距25mm左右,与培养皿边缘相距15mm以上。每个培养皿为一种防腐剂的4个浓度。用微量移液器吸取防腐剂6ul到孔内,让防腐剂刚好齐培养基面,盖好培养皿。
7、培养并观察抑菌效果
于37℃生化培养箱中正置培养,培养16-18小时观察结果。测量抑菌圈并记录。
四、实验结果
1、纸片法实验数据和图片
|
16h
|
防腐剂1
|
防腐剂2
|
防腐剂3
|
防腐剂4
|
P**300
|
|
1/250
|
2.2
|
2.0
|
1.9
|
2.1
|
1.4
|
|
1/500
|
1.7
|
1.7
|
1.5
|
1.7
|
1.1
|
|
1/1000
|
1.5
|
1.5
|
1.2
|
1.4
|
0.6
|
|
1/2000
|
0.6
|
0.8
|
0.9
|
1.2
|
0.5
|

2、打孔法实验数据和图片
打孔法(1/10)
|
16h
|
防腐剂1
|
防腐剂2
|
防腐剂3
|
防腐剂4
|
P**300
|
|
1/250
|
2.2
|
2.2
|
2.0
|
2.2
|
1.5
|
|
1/500
|
1.9
|
1.8
|
1.6
|
1.9
|
1.1
|
|
1/1000
|
1.5
|
1.5
|
1.4
|
1.5
|
0.9
|
|
1/2000
|
1.1
|
1.0
|
1.0
|
1.2
|
0.6
|
打孔法(1/2)
|
16h
|
防腐剂1
|
防腐剂2
|
防腐剂3
|
防腐剂4
|
P**300
|
|
1/250
|
2.2
|
2.0
|
1.9
|
2.1
|
1.5
|
|
1/500
|
1.8
|
1.7
|
1.6
|
1.7
|
1.2
|
|
1/1000
|
1.5
|
1.4
|
1.3
|
1.5
|
0.9
|
|
1/2000
|
1.1
|
1.0
|
1.1
|
1.1
|
0.5
|

结论
从两次实验结果来看,防腐剂P1-P4的抑菌效果都是优于对照P**300的抑菌效果。
从抑菌浓度来看,防腐剂P1-P4的1/1000的效果跟对照P**300的1/250的效果相当。
总结
总体来看,西宝的公司KV300之P1-P4批次的抑菌效果明显优于P**300,1:1000~1:2000高稀释倍数的抑菌效果差距明显。故建议具体使用浓度视溶液营养份而定,但不宜稀释过低。实验显示西宝KroVin300在细菌、霉菌、酵母菌的杀菌抑菌效果上明显优于某进口品牌的P**300。
相关文章
免费索样或咨询KroVin防腐剂信息,请致电 400-021-8158联系西宝生物。
KroVin系列防腐剂产品列表
| 物料编码 | 产品名称 | 包装规格 |
| ACN0054A | KroVin 100 | 100ml,500ml,1L |
| ACN0037B | KroVin 300 | 25ml,100ml,500ml,1L,5L |
| ACN0046A | KroVin 500 | 25ml,100ml,500ml,1L |
| ACN0043B | KroVin 950 | 25ml,100ml,500ml,1L,5L |
| ACN0911A | KroVin 1100 | 25ml,500ml,5L |
如果以上防腐剂都未能满足您的要求,可将您的样本体系寄给我司,我们将为您定制开发。


















